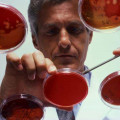

Լրահոս
 Լուսինե Աղաբեկյանն ասես իրոք տրանսֆեստիտ լինի
Լուսինե Աղաբեկյանն ասես իրոք տրանսֆեստիտ լինի
 «Նա երևույթ է իրենով...». Ավետ Բարսեղյանը` իր և իր կնոջ պատկերացրած ընտանեկան մոդելը կառուցելու մասին
«Նա երևույթ է իրենով...». Ավետ Բարսեղյանը` իր և իր կնոջ պատկերացրած ընտանեկան մոդելը կառուցելու մասին
 Ինչպես հաղթահարել արյան քաղցկեղը
Ինչպես հաղթահարել արյան քաղցկեղը
 Ո՞վ և ի՞նչ անակնկալ է մատուցել Լիկա Սալմանյանին՝ 20-ամյակի առթիվ
Ո՞վ և ի՞նչ անակնկալ է մատուցել Լիկա Սալմանյանին՝ 20-ամյակի առթիվ
 Տաթեւիկ Կարապետյան. Միլիարդատերի դուստրը` ինչպես կինոյում
Տաթեւիկ Կարապետյան. Միլիարդատերի դուստրը` ինչպես կինոյում
 Շոկոլադե տորթ 30 րոպեում
Շոկոլադե տորթ 30 րոպեում
 Մանրուքներ, որ փչացնում են ձեր կերպարը
Մանրուքներ, որ փչացնում են ձեր կերպարը
 Կոկոսի յուղը հրաշք միջոց, որն արժե փորձել
Կոկոսի յուղը հրաշք միջոց, որն արժե փորձել
 Մոտիվացիա.Հայ հայտնիների դպրոցական բարդույթները
Մոտիվացիա.Հայ հայտնիների դպրոցական բարդույթները
 Ինչո՞ւ է այդքան կարևոր յոդը
Ինչո՞ւ է այդքան կարևոր յոդը
 Տղամարդկանց մի քանի հատկանիշ, որոնք դուր են գալիս կանանց
Տղամարդկանց մի քանի հատկանիշ, որոնք դուր են գալիս կանանց
 10 փաստ ձեռքի ժամացույցների մասին
10 փաստ ձեռքի ժամացույցների մասին
 «Երեխայի սեռը չպետք է էական նշանակություն ունենա ...». Արփինե Իսրայելյանը` առաջնեկին սպասելու մասին
«Երեխայի սեռը չպետք է էական նշանակություն ունենա ...». Արփինե Իսրայելյանը` առաջնեկին սպասելու մասին
 Տաք ջուր խմելու օգտակարության մասին
Տաք ջուր խմելու օգտակարության մասին
 Դիանա Գրիգորյան.«Ընտանիքս սկսել է բողոքել»
Դիանա Գրիգորյան.«Ընտանիքս սկսել է բողոքել»
 Կինոթատրոնում այս տղային հաղորդագրություն եկավ. Այն, ինչ տեղի ունեցավ մեկ վայրկյան անց, շոկի ենթարկեց բոլորին (տեսանյութ)
Կինոթատրոնում այս տղային հաղորդագրություն եկավ. Այն, ինչ տեղի ունեցավ մեկ վայրկյան անց, շոկի ենթարկեց բոլորին (տեսանյութ)
 Ատրակցիոնների 10 ամենասարսափելի ողբերգությունները (տեսանյութ)
Ատրակցիոնների 10 ամենասարսափելի ողբերգությունները (տեսանյութ)
 Ո՞ր հայտնի դիզայների հետ է համագործակցելու Իվետա Մուկուչյանը
Ո՞ր հայտնի դիզայների հետ է համագործակցելու Իվետա Մուկուչյանը
 Մի խենթ սիրո պատմություն` լի ժպիտներով և երջանկությամբ (լուսանկար)
Մի խենթ սիրո պատմություն` լի ժպիտներով և երջանկությամբ (լուսանկար)
 Հիվանդ ուսուցչուհին չէր էլ կարող պատկերացնել, թե ինչ է իրեն սպասվում միջանցքում… (տեսանյութ)
Հիվանդ ուսուցչուհին չէր էլ կարող պատկերացնել, թե ինչ է իրեն սպասվում միջանցքում… (տեսանյութ)
 Կարինա Առուստամյանը՝ «The Band»-ի գործունեության, Բեյոնսեի երկու երգերի և հայկական էթնիկ երաժշտության միքսի ու նոր տեսահոլովակի մասին
Կարինա Առուստամյանը՝ «The Band»-ի գործունեության, Բեյոնսեի երկու երգերի և հայկական էթնիկ երաժշտության միքսի ու նոր տեսահոլովակի մասին
 Վյաչեսլավ Դոբրինինի դուստրը տիպիկ հայկական արտաքին ունի (լուսանկարներ)
Վյաչեսլավ Դոբրինինի դուստրը տիպիկ հայկական արտաքին ունի (լուսանկարներ)
 Հերմինե Ստեփանյան. «Իմ շատ սիրելի ռեժիսորների հետ եմ աշխատելու.նրանց հրավերին սպասել եմ ու երազել»
Հերմինե Ստեփանյան. «Իմ շատ սիրելի ռեժիսորների հետ եմ աշխատելու.նրանց հրավերին սպասել եմ ու երազել»
 «Սիրուշոն իմ կյանքում հանդիպած ամենահետաքրքիր մարդկանցից մեկն է...». Հրաչյա Հարությունյանն` անձնական երջանության մասին
«Սիրուշոն իմ կյանքում հանդիպած ամենահետաքրքիր մարդկանցից մեկն է...». Հրաչյա Հարությունյանն` անձնական երջանության մասին
 Էլեկտրոնային սիգարետը պայթել է տղամարդու գրպանում
(տեսանյութ)
Էլեկտրոնային սիգարետը պայթել է տղամարդու գրպանում
(տեսանյութ)
 Ավստրալիայում երկու մետրանոց պիթոնը հարձակվել է երեխայի վրա
Ավստրալիայում երկու մետրանոց պիթոնը հարձակվել է երեխայի վրա
 Հայկական շոու-բիզնեսի գեղեցկուհի թխահերները
Հայկական շոու-բիզնեսի գեղեցկուհի թխահերները
 Ալինա Մարտիրոսյանը՝ խորամանկ ու հաշվենկատ կին
Ալինա Մարտիրոսյանը՝ խորամանկ ու հաշվենկատ կին
 Ատամի մածուկի գաղտնիքը՝ թաքնված սրվակի ներքևի հատվածում
Ատամի մածուկի գաղտնիքը՝ թաքնված սրվակի ներքևի հատվածում
 6 բան, որ վանում է տղամարդուն կնոջից
6 բան, որ վանում է տղամարդուն կնոջից

 Գորիսի տարածաշրջանում թույլ ձյուն է տեղում
Գորիսի տարածաշրջանում թույլ ձյուն է տեղում
 Կապանում և մեր սահմաններին կրակոցներ չկան, բայց ձայներ լսվում են. Գևորգ Փարսյան
Կապանում և մեր սահմաններին կրակոցներ չկան, բայց ձայներ լսվում են. Գևորգ Փարսյան
 Ահա այս վարքագիծն ունի իշխանության «աթոռակը» կորցնելու վտանգն զգացող պաշտոնյան․ Աննա Կոստանյան
Ահա այս վարքագիծն ունի իշխանության «աթոռակը» կորցնելու վտանգն զգացող պաշտոնյան․ Աննա Կոստանյան Պարզվել է՝ ով է Արաբկիր համայնքում 13 մեքենա թալանել
Պարզվել է՝ ով է Արաբկիր համայնքում 13 մեքենա թալանել
 Ծեծկռտուք՝ 9-րդ դասարանի աշակերտների միջև․ տղաներից մեկը փայտե մուրճով հարվածել է մյուսի գլխին
Ծեծկռտուք՝ 9-րդ դասարանի աշակերտների միջև․ տղաներից մեկը փայտե մուրճով հարվածել է մյուսի գլխին
 Թալանի վերադարձ, թե նախընտրական շոու. ինչպես են մեզ մոլորեցնում ամեն օր. Էդմոն Մարուքյան
Թալանի վերադարձ, թե նախընտրական շոու. ինչպես են մեզ մոլորեցնում ամեն օր. Էդմոն Մարուքյան Հարի Քեյնը վնասվածք է ստացել
Հարի Քեյնը վնասվածք է ստացել
 2018-ից մինչ այսօր այս իշխանությունների անգործության հետևանքով Հայաստանում թմրամոլությունը անկառավարելիորեն աճել է՝ հատկապես երիտասարդների շրջանում. Նարեկ Կարապետյան
2018-ից մինչ այսօր այս իշխանությունների անգործության հետևանքով Հայաստանում թմրամոլությունը անկառավարելիորեն աճել է՝ հատկապես երիտասարդների շրջանում. Նարեկ Կարապետյան Պատերազմի սկզբից ի վեր Իրանն ավելի քան 500 հրթիռ և ավելի քան 2000 անօդաչու թռչող սարք է արձակել. Fars
Պատերազմի սկզբից ի վեր Իրանն ավելի քան 500 հրթիռ և ավելի քան 2000 անօդաչու թռչող սարք է արձակել. Fars
 Հրդեհ Մուշավան թաղամասում. կա տուժած
Հրդեհ Մուշավան թաղամասում. կա տուժած
 Էրդողանը զանգահարել է Ալիևին և աջակցություն հայտնել Ադրբեջանին
Էրդողանը զանգահարել է Ալիևին և աջակցություն հայտնել Ադրբեջանին
 Իրանը նոր հրթիռային համազարկ է արձակել. IRIB
Իրանը նոր հրթիռային համազարկ է արձակել. IRIB
 Երթևեկության փոփոխություն կկատարվի Անաստաս Միկոյան փողոցում
Երթևեկության փոփոխություն կկատարվի Անաստաս Միկոյան փողոցում
 Եղանակը Հայաստանում
Եղանակը Հայաստանում
 «Սենցասիոն» վաճառքներով հայտնի «Ֆուլ սայզը» սնանկ է ճանաչվել. նոր բացահայտումներ աղմկահարույց գործից
«Սենցասիոն» վաճառքներով հայտնի «Ֆուլ սայզը» սնանկ է ճանաչվել. նոր բացահայտումներ աղմկահարույց գործից
 Մենք առաջարկում ենք բերքի երաշխավորված մթերում գյուղերում․ Գոհար Ղումաշյան
Մենք առաջարկում ենք բերքի երաշխավորված մթերում գյուղերում․ Գոհար Ղումաշյան Իրանը հարվածել է Իրաքյան Քուրդիստանին
Իրանը հարվածել է Իրաքյան Քուրդիստանին
 Իրողություն, որը կփոխվի Սամվել Կարապետյանի վարչապետությամբ. Լենա Մաթևոսյան
Իրողություն, որը կփոխվի Սամվել Կարապետյանի վարչապետությամբ. Լենա Մաթևոսյան ՀՀ տարածքում կրակոցներ, պայթյուններ չեն արձանագրվել և չկան. ՊՆ
ՀՀ տարածքում կրակոցներ, պայթյուններ չեն արձանագրվել և չկան. ՊՆ
 Ապօրինի շրջանառությունից դուրս է բերվել 1 կգ-ից ավելի մարիխուանա․ ՆԳՆ ոստիկանություն
Ապօրինի շրջանառությունից դուրս է բերվել 1 կգ-ից ավելի մարիխուանա․ ՆԳՆ ոստիկանություն
 Արարատ Միրզոյանը հեռախոսազրույց է ունեցել Բահրեյնի Թագավորության ԱԳ նախարարի հետ
Արարատ Միրզոյանը հեռախոսազրույց է ունեցել Բահրեյնի Թագավորության ԱԳ նախարարի հետ
 Մեկնարկում ենք մեր նախընտրական ծրագրի հանրայնացումը. Նաիրի Սարգսյան
Մեկնարկում ենք մեր նախընտրական ծրագրի հանրայնացումը. Նաիրի Սարգսյան Իրանական բանակը հայտարարել է Թել Ավիվի վրա հարվածների մասին. իսրայելական ԱԹՍ է խփվել Կասր-է-Շիրինի օդում
Իրանական բանակը հայտարարել է Թել Ավիվի վրա հարվածների մասին. իսրայելական ԱԹՍ է խփվել Կասր-է-Շիրինի օդում
 Երաժշտական ուղին` նոր գործիքներով. «Ծնվել եմ Արցախում» ծրագրի մասնակիցները երաժշտական գործիքներ ստացան
Երաժշտական ուղին` նոր գործիքներով. «Ծնվել եմ Արցախում» ծրագրի մասնակիցները երաժշտական գործիքներ ստացան Ուժեղ Հայաստանում կլինի դատական իշխանություն՝ բառի լիարժեք իրավական բովանդակությամբ. Արթուր Դանիելյան
Ուժեղ Հայաստանում կլինի դատական իշխանություն՝ բառի լիարժեք իրավական բովանդակությամբ. Արթուր Դանիելյան Ադրբեջան-Իրան սահմանին բեռնատարների երթևեկությունը լիովին դադարեցվել է
Ադրբեջան-Իրան սահմանին բեռնատարների երթևեկությունը լիովին դադարեցվել է
 Սամվել Կարապետյանից վախերն արտահայտվում են այլևս 260 օր տևող ազատության ինտենսիվ ապօրինի սահմանափակմամբ. Արամ Վարդևանյան
Սամվել Կարապետյանից վախերն արտահայտվում են այլևս 260 օր տևող ազատության ինտենսիվ ապօրինի սահմանափակմամբ. Արամ Վարդևանյան Լիբանանցիները Իսրայելի սպառնալիքի պատճառով զանգվածաբար փախչում են Բեյրութի հարավից. ТАСС
Լիբանանցիները Իսրայելի սպառնալիքի պատճառով զանգվածաբար փախչում են Բեյրութի հարավից. ТАСС
 Իրանի հետ պատերազմից Իսրայելի տնտեսությանը հասցված վնասը հասնում է մոտ 3 միլիարդ դոլարի. Ֆինանսների նախարարություն
Իրանի հետ պատերազմից Իսրայելի տնտեսությանը հասցված վնասը հասնում է մոտ 3 միլիարդ դոլարի. Ֆինանսների նախարարություն
 Վանաձորի շենքերից մեկում հրդեհ է բռնկվել
Վանաձորի շենքերից մեկում հրդեհ է բռնկվել
 Վարդենյաց լեռնանցքը և Թթուջուր-Նավուր ավտոճանապարհը դժվարանցանելի են կցորդով տրանսպորտային միջոցների համար
Վարդենյաց լեռնանցքը և Թթուջուր-Նավուր ավտոճանապարհը դժվարանցանելի են կցորդով տրանսպորտային միջոցների համար
 ԱՄՆ-ում մերժել են Թրամփի ռազմական լիազորությունները սահմանափակող բանաձևը
ԱՄՆ-ում մերժել են Թրամփի ռազմական լիազորությունները սահմանափակող բանաձևը
 Խոշոր ավտովթար․ կան վիրավորներ
Խոշոր ավտովթար․ կան վիրավորներ
 «Նրա անունը բոլորիս սրտերում է».Հովհաննես Ծառուկյանը հերոս տղաների հետ խոնարհվել է Սպարապետի շիրիմին
«Նրա անունը բոլորիս սրտերում է».Հովհաննես Ծառուկյանը հերոս տղաների հետ խոնարհվել է Սպարապետի շիրիմին Կրեմլը բարձր է գնահատում ԱՄՆ-ի դերը Ուկրաինայի շուրջ բանակցություններում
Կրեմլը բարձր է գնահատում ԱՄՆ-ի դերը Ուկրաինայի շուրջ բանակցություններում
 Քո սեփական բնակարանը՝ վարձակալության գնով. Սա Հայաստանի հաջորդ վարչապետ Սամվել Կարապետյանի ծրագիրն է
Քո սեփական բնակարանը՝ վարձակալության գնով. Սա Հայաստանի հաջորդ վարչապետ Սամվել Կարապետյանի ծրագիրն է «Ռեալն» ու Մբապեն ունեն տարաձայնություններ
«Ռեալն» ու Մբապեն ունեն տարաձայնություններ
 Կատարը տարհանում է ԱՄՆ դեսպանատան մոտ գտնվող տարածքը
Կատարը տարհանում է ԱՄՆ դեսպանատան մոտ գտնվող տարածքը
 Միրզոյանը Բահրեյնի ԱԳ նախարարի հետ քննարկել է Մերձավոր Արևելքում ստեղծված իրադրությունը
Միրզոյանը Բահրեյնի ԱԳ նախարարի հետ քննարկել է Մերձավոր Արևելքում ստեղծված իրադրությունը
 Մարտի 6-ին Մասկատ-Երևան թռիչքի ուղևորների համար կկազմակերպվի անվճար տեղափոխում Աբու Դաբիից և Դուբայից
Մարտի 6-ին Մասկատ-Երևան թռիչքի ուղևորների համար կկազմակերպվի անվճար տեղափոխում Աբու Դաբիից և Դուբայից
 Արմլիզինգի պարտատոմսերը՝ բորսայում. Տեղաբաշխողը Կոնվերս Բանկն է
Արմլիզինգի պարտատոմսերը՝ բորսայում. Տեղաբաշխողը Կոնվերս Բանկն է Մերձավոր Արևելքի ճգնաժամը կարող է լուրջ ռիսկ դառնալ եվրոյի համար
Մերձավոր Արևելքի ճգնաժամը կարող է լուրջ ռիսկ դառնալ եվրոյի համար
 Պարեկները գիշերային ծառայության ժամանակ թմրամիջոցի իրացման դեպք են բացահայտել
Պարեկները գիշերային ծառայության ժամանակ թմրամիջոցի իրացման դեպք են բացահայտել
 Ռոնալդուն բաց կթողնի 2–4 շաբաթ
Ռոնալդուն բաց կթողնի 2–4 շաբաթ
 Իրան–Ադրբեջան լարվածության ֆոնին Փաշինյանն ԱԽ նիստ է անցկացրել
Իրան–Ադրբեջան լարվածության ֆոնին Փաշինյանն ԱԽ նիստ է անցկացրել
 Քրեական աստիճանակարգության կարգավիճակ ունեցող մի անձ պահանջել է 250 հզր դոլար, մյուսը՝ հարկադրել է սուտ ցուցմունք տալ․ ՔԿ
Քրեական աստիճանակարգության կարգավիճակ ունեցող մի անձ պահանջել է 250 հզր դոլար, մյուսը՝ հարկադրել է սուտ ցուցմունք տալ․ ՔԿ
 Հայաստանում սնունդը կթանկանա՞. ի՞նչ են կանխատեսում մասնագետները
Հայաստանում սնունդը կթանկանա՞. ի՞նչ են կանխատեսում մասնագետները
 Չկասկածեք սա ևս հաղթահարելու ենք և հաղթանակներ շատ են լինելու. Արամ Վարդևանյան
Չկասկածեք սա ևս հաղթահարելու ենք և հաղթանակներ շատ են լինելու. Արամ Վարդևանյան ԱՄԷ-ում թռիչքների չեղարկումից հետո խնդիրների բախված ՀՀ քաղաքացիներին դեսպանատունը կոչ է անում լրացնել տվյալները
ԱՄԷ-ում թռիչքների չեղարկումից հետո խնդիրների բախված ՀՀ քաղաքացիներին դեսպանատունը կոչ է անում լրացնել տվյալները
Իրանի ԶՈՒ գլխավոր շտաբը հերքել է Ադրբեջանի ուղղությամբ անօդաչու թռչող սարք արձակելու մասին տեղեկությունը
Իրանի ԶՈՒ գլխավոր շտաբը հերքել է Ադրբեջանի ուղղությամբ անօդաչու թռչող սարք արձակելու մասին տեղեկությունը






